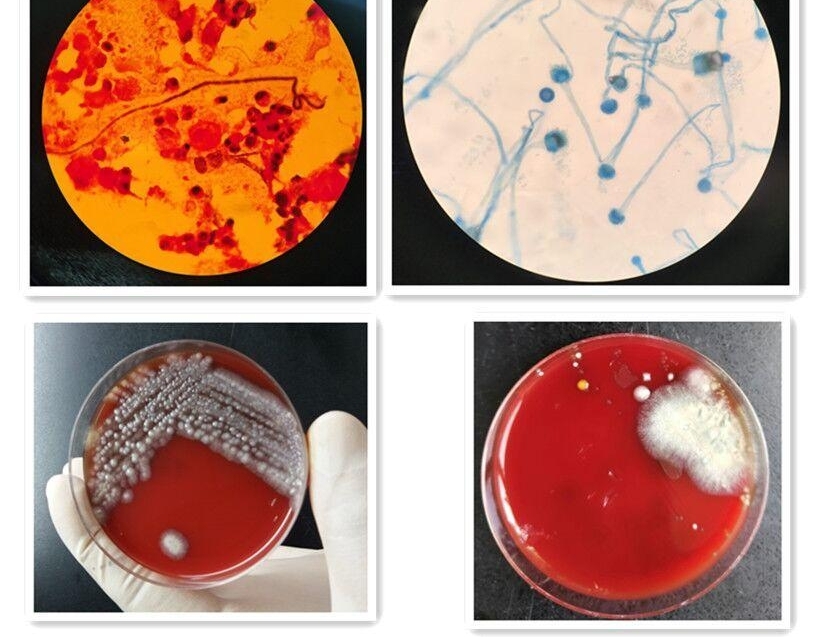
»2Ůβ ǷΡù

新会2岁女孩久治不愈 竟是肺“长霉”了

过期食物、潮湿环境长霉比较常见,但是肺“长霉”你有听说过吗?近日,江门市妇幼保健院接诊了首例肺曲霉菌病患者,发现曲霉菌竟然在该名患者的肺里“安了家”。
两岁三个月大的玲玲家在新会,一个多月前,父母觉得她有些异样。玲玲爸爸说:“之前孩子感冒了,有点低烧,打了针过后两三天又发烧,那一晚发烧高达39度多,后来才转到江门市妇幼保健院治疗。”
玲玲爸爸表示,玲玲在转院之前已经反复发烧12天,呼吸比较急促,精神也不太好。在转到市妇幼保健院后,医院迅速组织全科医生大会诊,共同为玲玲研究制定治疗方案。
该院儿科副主任医师吴振波说:“我们先给孩子做了CT,从CT中发现她两边肺的炎症都比较厉害。随后我们给她做了气管镜的检查,发现大量的痰塞住了气管的一些出口。在气管镜下我们取了标本,拿了这些标本做化验,发现有真菌,第三天左右,结果显示培养出来的是烟曲霉菌。”
最终,医生确诊玲玲感染了烟曲霉菌。找到致病原因后,医生对症下药,经过3周多的抗真菌治疗,玲玲的病情终于得到了控制。
医生表示,烟曲霉菌是曲霉菌的一种,属于真菌,毒性较强。烟曲霉菌最主要存在于阴暗潮湿的地方,或者发霉的一些食物、土壤里,如果人体免疫力正常的话,自然感染的情况下是比较少见的。
吴振波表示,会诊医生认为玲玲可能不是第一时间感染的真菌,而是因感冒发烧被普通的病毒感染后,降低了她的抵抗力,有可能在这个基础上合并真菌感染。
该院医生介绍,曲霉菌无处不在,除了免疫力低下的人群要注意,还有两类高危人群要格外注意:一是常年居住或工作在潮湿、不通风环境的人群;二是在工作中接触大量灰尘的人。
吴振波建议道:“如果知道自己的抵抗力不好的话,就少去人多人杂的地方。如果一定要去这些地方或者外出的时候,建议带个口罩。其次家居卫生要做好,比如一些卫生死角,要及时清洁。再次,对于长时间放置的物品,有可能会发霉,要及时清理,特别是发霉的食物千万不能吃。”
(江门台记者李子君 编辑丁田发)
内容简介
新会2岁女孩久治不愈 竟是肺“长霉”了
- 上一篇:他们专挑独居老人下手:78岁大爷一天被骗40万元
- 下一篇:没有了























